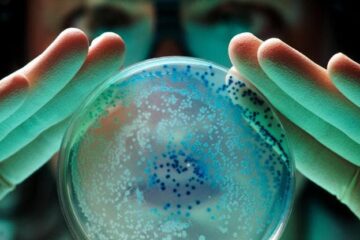

News
In Germania salari più alti, ma Sanità sotto stress: “La mia esperienza di medico italiano all’estero”
Ho letto con interesse le parole del Governatore Fabio Panetta sul capitale umano e sul divario retributivo tra giovani laureati italiani e tedeschi. È vero: in Germania si guadagna di…
News
Entro 10 anni il 60% dei farmaci sarà sviluppato con l’intelligenza artificiale
Entro dieci anni il 60% dei nuovi farmaci potrà essere progettato con l’intelligenza artificiale. È la previsione contenuta nel nuovo rapporto del Capgemini Research Institute dedicato alla trasformazione digitale del…
News
Il conto salato delle cure a cani e gatti: spese raddoppiate in 9 anni, il peso dei farmaci più cari
n Italia ci sono 22,5 milioni di animali da compagnia che vivono stabilmente nelle case degli italiani: secondo l’Istat 10 milioni di famiglie – in pratica una su quattro -…
News
Dai gemelli digitali ai nuovi bersagli per terapie contro Alzheimer e Parkinson: con il progetto Mnesys balzo italiano sulle neuroscienze
«Con oltre 800 scienziati coinvolti e grazie ai 65 centri che si sono aggiunti ai 25 soci fondatori, fra cui l’Università di Genova capofila del progetto, sono stati raggiunti risultati…